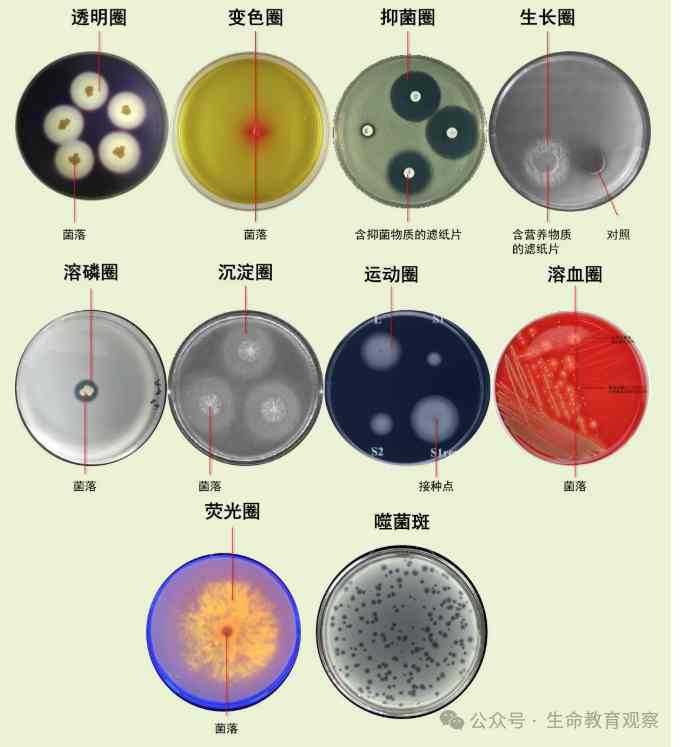

来源公众号:生命教育观察
在微生物学实验室里,培养皿中那些形态各异的“圈”,是科学家们破译微生物特性的关键密码。这些看似简单的圆形图案,实则蕴含着微生物代谢、生长、抗性等核心信息,是筛选优良菌株、开发新型药物、解析生命机制的重要窗口。
代谢能力的“显色圈”
当微生物分解培养基中的特定物质时,会形成特征性的“圈”。例如,在淀粉培养基上,能分泌淀粉酶的菌落周围会出现透明圈,这是因为淀粉被分解后,遇碘液不再变蓝;在含碳酸钙的培养基中,产酸菌落周围会形成溶钙圈,碳酸钙被酸溶解后呈现透明区域;在油脂培养基上,脂肪酶阳性菌株周围则会出现乳白色的水解圈。
这些“圈”的大小直接反映微生物的代谢能力。透明圈直径与菌落直径的比值(H/C值)越大,说明菌株产酶能力越强,是筛选高产酶菌株的重要指标。
抗性与抑制的“抑菌圈”
在抗生素筛选或抗菌物质检测中,抑菌圈是最直观的指标。将含抗菌物质的滤纸片贴在接种了测试菌的培养基上,若物质有效,周围会形成无菌生长的透明圈。圈的大小与抗菌物质的浓度、扩散能力及菌株敏感性相关。
值得注意的是,抑菌圈并非绝对“无菌”。某些耐药菌可能在圈内形成微小菌落,提示存在低水平耐药性。此外,抑菌圈实验需严格控制滤纸片大小、培养基厚度等变量,以确保结果可比性。
生长需求的“营养圈”
微生物的生长离不开特定营养物质。在缺乏某营养物的培养基上,只有能合成该物质或利用替代物的菌株才能生长,形成“生长圈”。例如,在缺乏氨基酸的培养基中,能合成该氨基酸的菌株周围会出现菌落密集区;在含难降解有机物的培养基中,能利用该有机物的菌株周围会形成明显的生长晕。
这种“营养圈”现象常用于筛选营养缺陷型菌株或降解污染物的功能菌。通过对比不同培养基上的生长圈,可快速判断菌株的营养需求和代谢途径。
特殊生理的“特征圈”
某些微生物会产生独特的生理现象,形成具有诊断价值的“圈”。例如,溶血圈是链球菌等病原菌在血平板上形成的透明或绿色区域,反映其溶血能力;荧光圈则是某些假单胞菌在紫外光下分泌的荧光色素,可用于快速鉴定;噬菌斑是噬菌体裂解宿主菌后形成的透明斑,是噬菌体研究和细菌分型的重要工具。
这些“特征圈”不仅是微生物分类鉴定的依据,也为疾病诊断和生物防治提供了重要线索。例如,溶血圈的形态可区分链球菌的致病性,噬菌斑的大小和形态可用于噬菌体效价测定。

运动与扩散的“动力圈”
在半固体培养基中,具有运动能力的细菌会从接种点向四周扩散,形成“运动圈”。这种“圈”的大小反映细菌的运动能力,常用于筛选具有趋化性或运动性的菌株。例如,某些根瘤菌通过运动圈筛选可获得侵染植物能力更强的菌株。
此外,某些微生物分泌的胞外多糖或生物膜也会在培养基表面形成扩散圈,这种现象在环境微生物学中用于研究微生物的定殖和扩散机制。

科学筛选的“圈”逻辑
微生物筛选中的“圈”本质上是微生物与环境相互作用的可视化结果。科学家们通过设计特定的培养基和实验条件,让目标微生物的“圈”特征显现,从而实现高效筛选。例如,在筛选抗生素产生菌时,会先用淀粉培养基筛选产酶菌,再用抑菌圈实验验证其抗菌活性;在筛选降解菌时,会以目标污染物为唯一碳源,通过生长圈判断降解能力。
随着高通量筛选技术的发展,“圈”的观察已从肉眼判断转向自动化图像分析,结合机器学习算法,可快速处理成千上万的培养皿图像,大幅提升筛选效率。
来源网址:微生物筛选中出现的各种“圈”




 扫码安装网站APP(Android版)
扫码安装网站APP(Android版)


近期评论